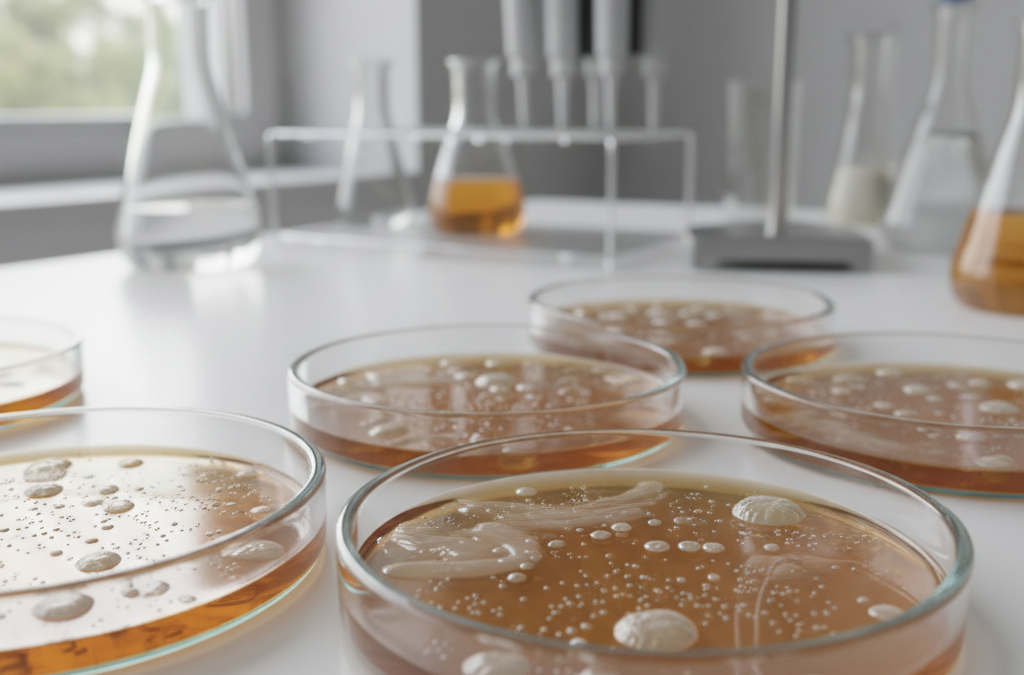

- Pilotowe badanie przetestowało kompleksy odżywcze dostępne dla mikrobioty jelitowej w celu spowolnienia biologicznego starzenia u zdrowych dorosłych.
- Badanie skupiło się na przedłużeniu healthspanu, czyli okresu zdrowego życia, poprzez celowanie w wiek biologiczny.
- Przeprowadzone przez zespół rumuńskich naukowców z Uniwersytetu Medycyny i Farmacji w Craiowie.
- Opublikowane w czasopiśmie Scientific Reports w grudniu 2025 roku.
Co to jest badanie pilotażowe?
Pilotowe badanie opublikowane w czasopiśmie Scientific Reports zbadało wpływ bioaktywnych kompleksów odżywczych na wiek biologiczny. Te kompleksy są dostępne dla mikrobioty jelitowej i skierowane do zdrowych dorosłych medycznie. Celem było przedłużenie healthspanu, czyli okresu życia w dobrym zdrowiu.
Badanie nosi tytuł „Targeting biological age with bioactive, microbiota-accessible nutritional complexes: a pilot study on healthspan extension in medically healthy adults”. Opublikowano je 23 grudnia 2025 roku z numerem DOI: 10.1038/s41598-025-31590-1.
Zespół badawczy i instytucje
Badanie poprowadził Andrei Biţă wraz z zespołem naukowców z Rumunii. Głównym miejscem pracy był Uniwersytet Medycyny i Farmacji w Craiovie, w tym Centrum Badań nad Lekami na Wydziale Farmacji.
Inni autorzy to Adina Turcu-Ştiolică, Ion Romulus Scorei, Cătălina Gabriela Pisoschi, Cristina Elena Biţă, Gabriela Rău, Maria Viorica Ciocîlteu, Simona Ştefănescu, Laura Dincă, Johny Neamţu, Ion Rogoveanu, George Dan Mogoşanu i Dan Ionuţ Gheonea. Pochodzą z różnych wydziałów, takich jak farmakognozja, biochemia, reumatologia czy gastroenterologia.
Główne instytucje zaangażowane
- Uniwersytet Medycyny i Farmacji w Craiovie (Wydział Farmacji i Medycyny, ul. Petru Rareş 2).
- Instytut Badań BioBoron, Podari.
- Szpital Kliniczny w Craiovie.
- Uniwersytet Medycyny i Farmacji „Iuliu Haţieganu” w Kluż-Napoce.
Publikacja i dane dostępności
Artykuł jest dostępny w PubMed z numerem PMID: 41436826 i PMCID: PMC12804831. Pełny tekst znajduje się na platformie Nature Publishing Group oraz w PMC jako artykuł bezpłatny.
Badanie podkreśla potencjał odżywczych interwencji w kontekście starzenia biologicznego, choć jako pilotowe wymaga dalszych potwierdzeń.
Źródło: Oryginalny artykuł

Komentarze czytelników 0
Bądź pierwszą osobą, która podzieli się opinią!
Twoje doświadczenie może pomóc innym — napisz, co myślisz o tym temacie.
💬 Co sądzisz? Podziel się swoją opinią
Twój komentarz zostanie opublikowany po moderacji. Adres email nie będzie widoczny.